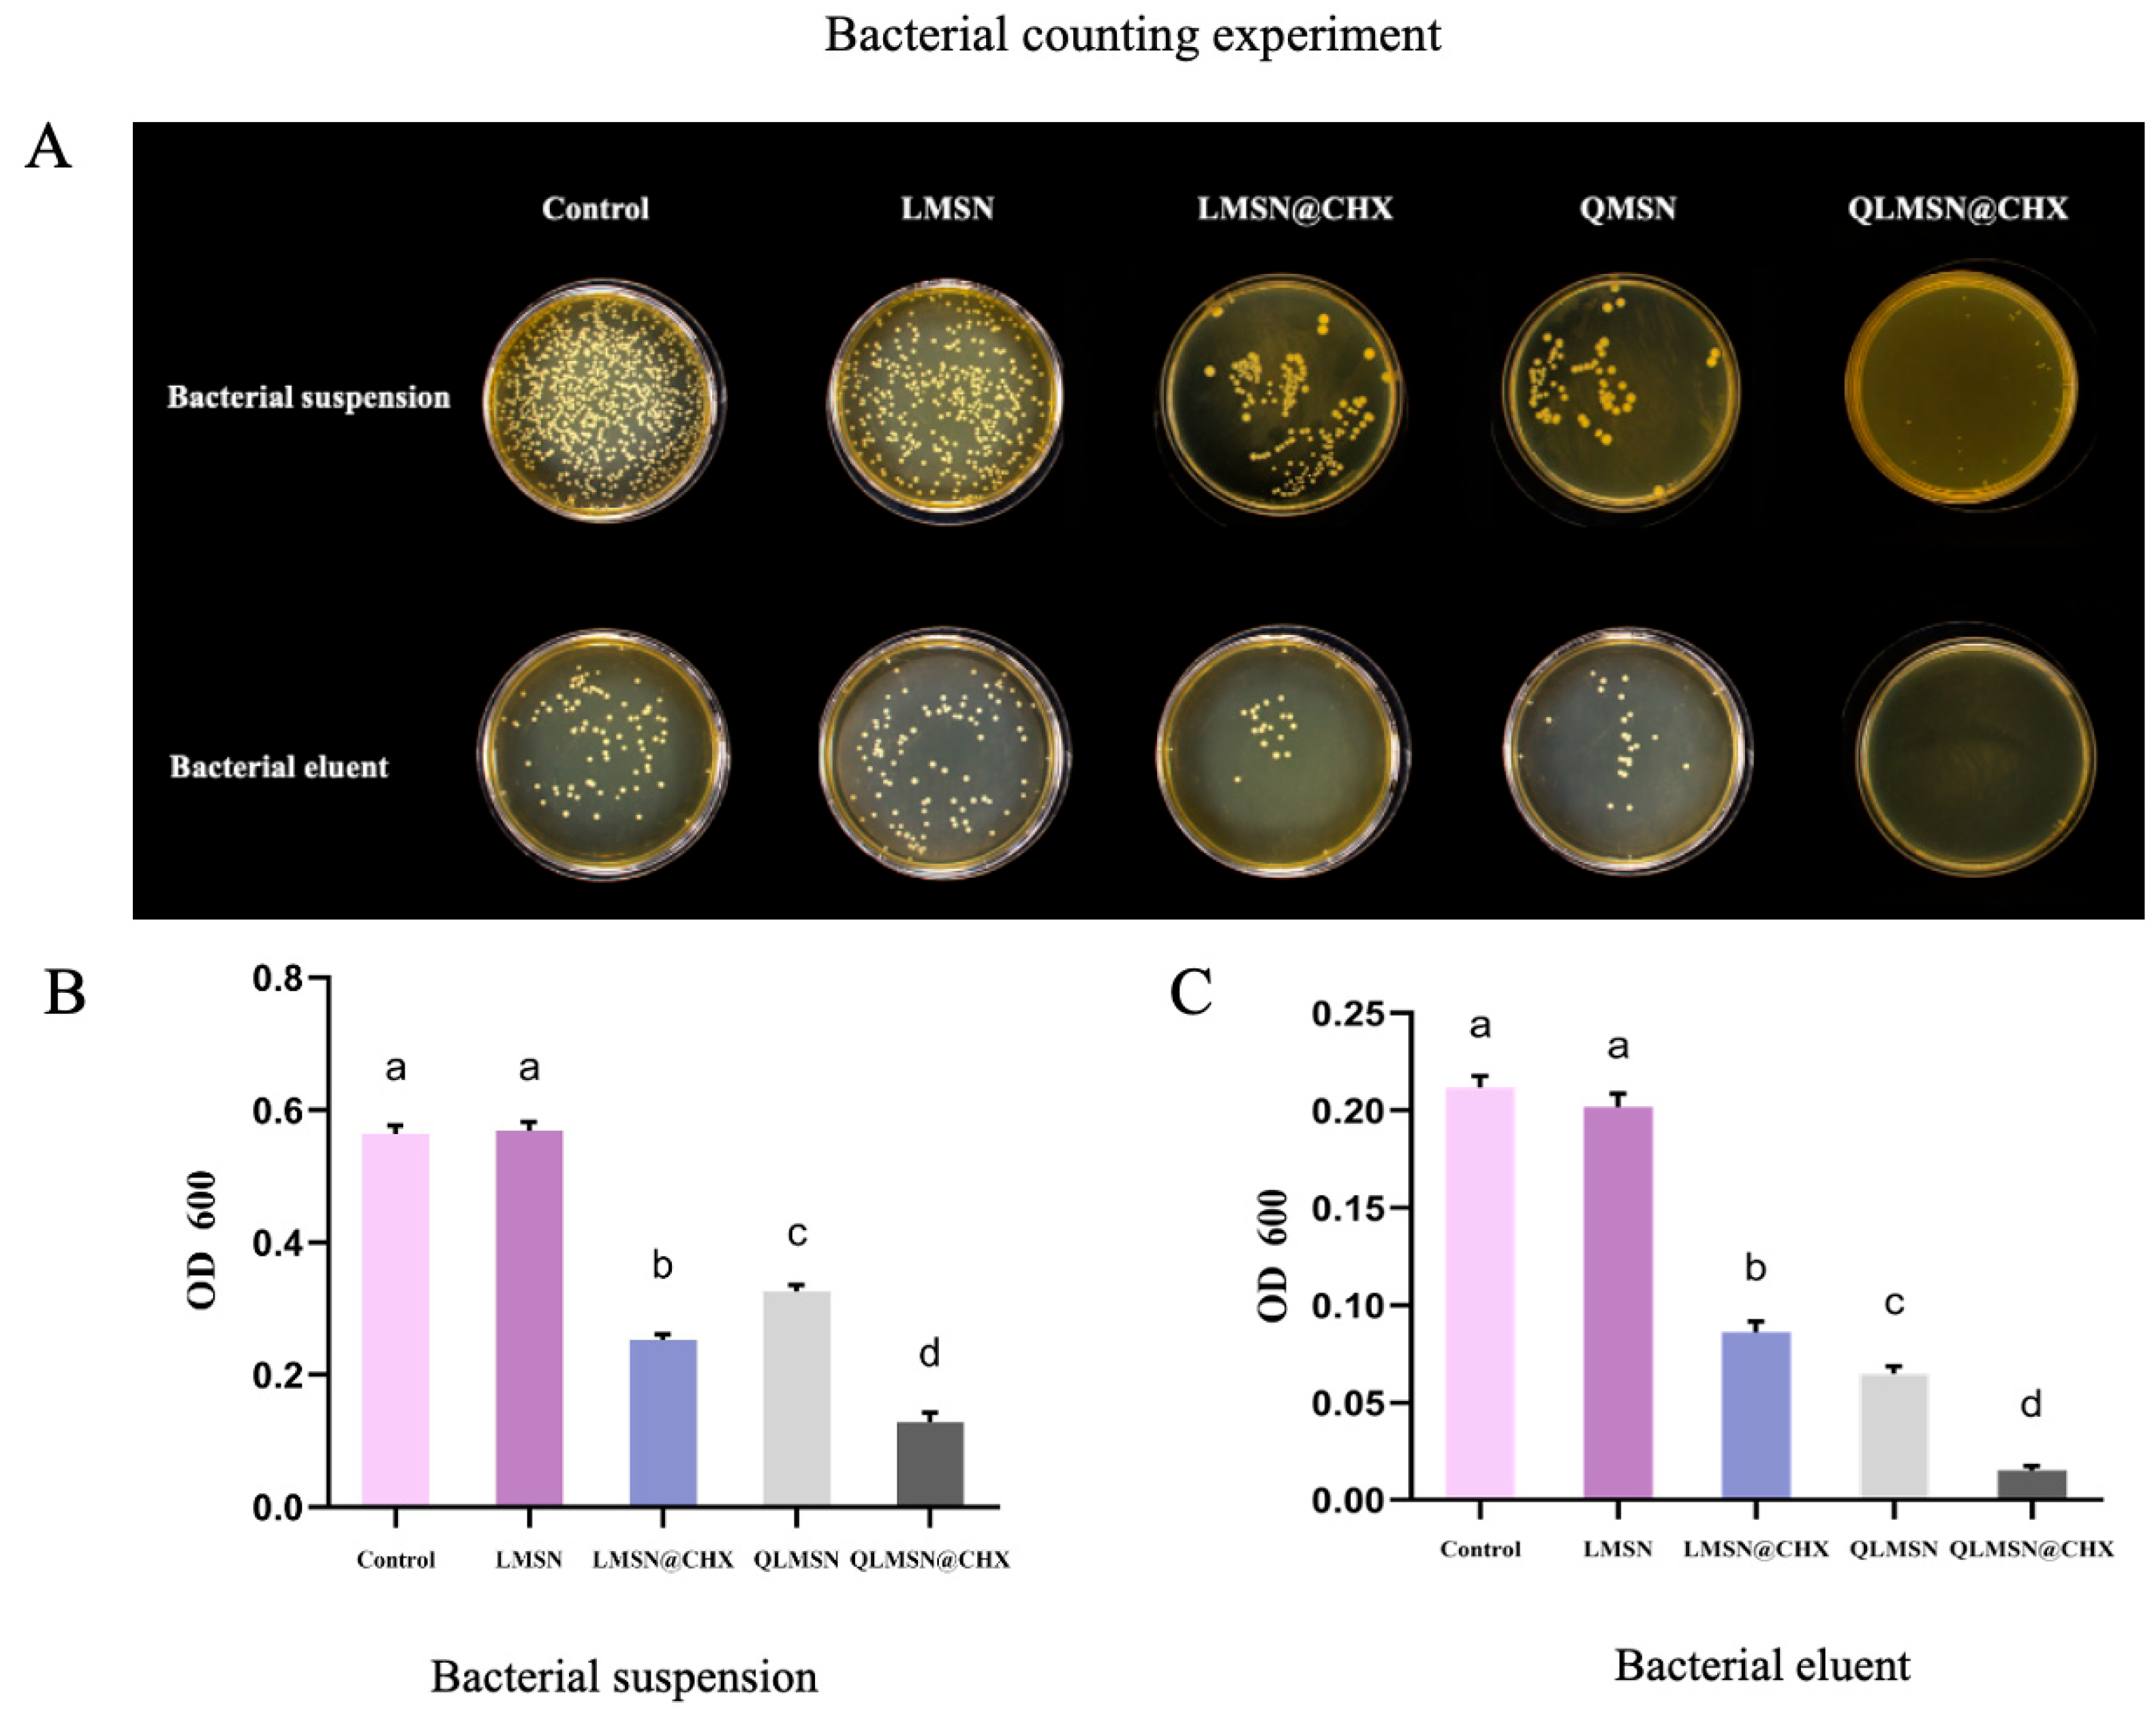
Ijms 26 06172 g004

Dual-Mode Antibacterial Orthodontic Composite: Contact-Killing QACs and Sustained CHX Release via Large-Pore Mesoporous Silica Nanoparticles
Abstract
1. Introduction
2. Results
2.1. Characterization of Different Nanoparticles (MSN, LMSN, QLMSN, and QLMSN@CHX)
2.1.1. TEM
2.1.2. FTIR
2.1.3. Drug Loading Release and Surface Graft Stability of Modified Macroporous Silica
2.1.4. Antibacterial Property Analysis
2.2. Analysis of Dual-Mode Antimicrobial
2.3. Resin Mechanical Properties
2.3.1. Modulus of Elasticity and Bending Performance
2.3.2. Shear Bond Strength
2.3.3. Water Absorption
2.3.4. Resin Residual Index (ARI)
3. Discussion
4. Materials and Methods
4.1. Synthesis of Large-Pore-Size Mesoporous Silica (LMSN)
4.2. Synthesis of Quaternary Ammonium-Modified Mesoporous Silica (QLMSN)
4.3. Preparation of Chlorhexidine-Loaded QLMSN (QLMSN@CHX)
4.4. Characterization of LMSN, QLMSN, and QLMSN@CHX
4.4.1. Transmission Electron Microscopy (TEM)
4.4.2. Fourier-Transform Infrared Spectroscopy (FTIR)
4.4.3. Thermogravimetry and Differential Thermal Analysis (TG/DTA)
4.4.4. X-Ray Photoelectron Spectroscopy (XPS)
4.4.5. Stability of QLMSN
4.4.6. Chlorhexidine Acetate Release from QLMSN@CHX
4.5. Cytotoxicity Test
4.6. Synthesis of the Composite Resin
4.7. Bacteria Inoculation and Biofilm Formation
4.8. Bacterial Counting Experiment
4.9. Agar Diffusion Assay for Antibacterial Activity
4.9.1. MTT Biofilm Assay
4.9.2. Live/Dead Bacterial Detection
4.10. Test of Resin Mechanical Properties
4.10.1. Modulus of Elasticity
4.10.2. Test of Shear Bond Strength
4.10.3. Resin Water Absorption
4.10.4. Adhesive Residue Index (ARI)
4.11. Statistical Analysis
5. Conclusions
6. Patents
Supplementary Materials
Author Contributions
Funding
Institutional Review Board Statement
Informed Consent Statement
Data Availability Statement
Acknowledgments
Conflicts of Interest
References
- Hu, H.; Feng, C.; Jiang, Z.; Wang, L.; Shrestha, S.; Yan, J.; Shu, Y.; Ge, L.; Lai, W.; Hua, F.; et al. Effectiveness of remineralizing agents in the prevention and reversal of orthodontically induced white spot lesions: A systematic review and network meta-analysis. Clin. Oral Investig. 2020, 24, 4153–4167. [Google Scholar] [CrossRef] [PubMed]
- Saiprasert, P.; Tansakul, C.; Pikulngam, A.; Promphet, P.; Naorungroj, S.; Ratanasathien, S.; Aksornmuang, J.; Talungchit, S. Novel hydrolytic resistant antibacterial monomers for dental resin adhesive. J. Dent. 2023, 135, 104597. [Google Scholar] [CrossRef] [PubMed]
- Sonesson, M.; Brechter, A.; Abdulraheem, S.; Lindman, R.; Twetman, S. Fluoride varnish for the prevention of white spot lesions during orthodontic treatment with fixed appliances: A randomized controlled trial. Eur. J. Orthod. 2020, 42, 326–330. [Google Scholar] [CrossRef]
- Wu, L.; Wei, S.; Cheng, X.; He, N.; Kang, X.; Zhou, H.; Cai, Y.; Ye, Y.; Li, P.; Liang, C. Release of ions enhanced the antibacterial performance of laser-generated, uncoated Ag nanoparticles. Colloids Surf. B Biointerfaces 2024, 243, 114131. [Google Scholar] [CrossRef] [PubMed]
- Yin, I.X.; Zhang, J.; Zhao, I.S.; Mei, M.L.; Li, Q.; Chu, C.H. The Antibacterial Mechanism of Silver Nanoparticles and Its Application in Dentistry. Int. J. Nanomed. 2020, 15, 2555–2562. [Google Scholar] [CrossRef]
- Nicolae-Maranciuc, A.; Chicea, D.; Chicea, L.M. Ag Nanoparticles for Biomedical Applications-Synthesis and Characterization-A Review. Int. J. Mol. Sci. 2022, 23, 5778. [Google Scholar] [CrossRef]
- Zheng, H.; Zhong, B.; Wang, Q.; Li, X.; Chen, J.; Liu, L.; Liu, T. ZnO-Doped Metal-Organic Frameworks Nanoparticles: Antibacterial Activity and Mechanisms. Int. J. Mol. Sci. 2023, 24, 12238. [Google Scholar] [CrossRef]
- Tanweer, T.; Rana, N.F.; Saleem, I.; Shafique, I.; Alshahrani, S.M.; Almukhlifi, H.A.; Alotaibi, A.S.; Alshareef, S.A.; Menaa, F. Dental Composites with Magnesium Doped Zinc Oxide Nanoparticles Prevent Secondary Caries in the Alloxan-Induced Diabetic Model. Int. J. Mol. Sci. 2022, 23, 15926. [Google Scholar] [CrossRef]
- Huq, M.A.; Apu, M.A.I.; Ashrafudoulla, M.; Rahman, M.M.; Parvez, M.A.K.; Balusamy, S.R.; Akter, S.; Rahman, M.S. Bioactive ZnO Nanoparticles: Biosynthesis, Characterization and Potential Antimicrobial Applications. Pharmaceutics 2023, 15, 2634. [Google Scholar] [CrossRef]
- Larissa, P.; Gambrill, B.; de Carvalho, R.D.P.; Picolo, M.Z.D.; Cavalli, V.; Boaro, L.C.C.; Prokopovich, P.; Cogo-Müller, K. Development, characterization and antimicrobial activity of multilayer silica nanoparticles with chlorhexidine incorporated into dental composites. Dent. Mater. 2023, 39, 469–477. [Google Scholar] [CrossRef]
- Cao, L.; Yan, J.; Luo, T.; Yan, H.; Hua, F.; He, H. Antibacterial and fluorescent clear aligner attachment resin modified with chlorhexidine loaded mesoporous silica nanoparticles and zinc oxide quantum dots. J. Mech. Behav. Biomed. Mater. 2023, 141, 105817. [Google Scholar] [CrossRef]
- Ren, J.; Guo, X. The germicidal effect, biosafety and mechanical properties of antibacterial resin composite in cavity filling. Heliyon 2023, 9, e19078. [Google Scholar] [CrossRef] [PubMed]
- Zhou, W.; Peng, X.; Zhou, X.; Bonavente, A.; Weir, M.D.; Melo, M.A.S.; Imazato, S.; Oates, T.W.; Cheng, L.; Xu, H.H.K. Novel Nanocomposite Inhibiting Caries at the Enamel Restoration Margins in an In Vitro Saliva-Derived Biofilm Secondary Caries Model. Int. J. Mol. Sci. 2020, 21, 6369. [Google Scholar] [CrossRef]
- Jiao, Y.; Tay, F.R.; Niu, L.N.; Chen, J.H. Advancing antimicrobial strategies for managing oral biofilm infections. Int. J. Oral Sci. 2019, 11, 28. [Google Scholar] [CrossRef] [PubMed]
- Schmidt, J.; Krohn, S.; Kallies, R.; Schneider, H.; Zeller, K.; Ziebolz, D.; Berg, T.; Haak, R. Antibacterial effect of a brominated self-etch adhesive on carious dentin—An in vivo study. J. Dent. 2021, 105, 103555. [Google Scholar] [CrossRef]
- Alhussein, A.; Alsahafi, R.; Wang, X.; Mitwalli, H.; Filemban, H.; Hack, G.D.; Oates, T.W.; Sun, J.; Weir, M.D.; Xu, H.H.K. Novel Dental Low-Shrinkage-Stress Composite with Antibacterial Dimethylaminododecyl Methacrylate Monomer. J. Funct. Biomater. 2023, 14, 335. [Google Scholar] [CrossRef]
- Dan, W.; Gao, J.; Qi, X.; Wang, J.; Dai, J. Antibacterial quaternary ammonium agents: Chemical diversity and biological mechanism. Eur. J. Med. Chem. 2022, 243, 114765. [Google Scholar] [CrossRef]
- Bai, Y.M.; Mao, J.; Li, D.X.; Luo, X.J.; Chen, J.; Tay, F.R.; Niu, L.N. Bimodal antibacterial system based on quaternary ammonium silane-coupled core-shell hollow mesoporous silica. Acta Biomater. 2019, 85, 229–240. [Google Scholar] [CrossRef]
- Gao, S.; Sun, Y.; Lu, Z.; Jiang, N.; Yao, H. Synergistic antibacterial and biofilm eradication activity of quaternary-ammonium compound with copper ion. J. Inorg. Biochem. 2023, 243, 112190. [Google Scholar] [CrossRef] [PubMed]
- Zhang, W.; Luo, X.J.; Niu, L.N.; Liu, S.Y.; Zhu, W.C.; Epasinghe, J.; Chen, L.; Li, G.H.; Huang, C.; Mao, J.; et al. One-pot synthesis of antibacterial monomers with dual biocidal modes. J. Dent. 2014, 42, 1078–1095. [Google Scholar] [CrossRef]
- Yan, H.; Yang, H.; Li, K.; Yu, J.; Huang, C. Effects of Chlorhexidine-Encapsulated Mesoporous Silica Nanoparticles on the Anti-Biofilm and Mechanical Properties of Glass Ionomer Cement. Molecules 2017, 22, 1225. [Google Scholar] [CrossRef] [PubMed]
- Kamal, T.; Khalil, A.; Bakhsh, E.M.; Khan, S.B.; Chani, M.T.S.; Ul-Islam, M. Efficient fabrication, antibacterial and catalytic performance of Ag-NiO loaded bacterial cellulose paper. Int. J. Biol. Macromol. 2022, 206, 917–926. [Google Scholar] [CrossRef] [PubMed]
- Wu, M.X.; Wang, X.; Yang, Y.W. Polymer Nanoassembly as Delivery Systems and Anti-Bacterial Toolbox: From PGMAs to MSN@PGMAs. Chem. Rec. 2018, 18, 45–54. [Google Scholar] [CrossRef] [PubMed]
- Fan, H.; Xing, X.; Yang, Y.; Li, B.; Wang, C.; Qiu, D. Triple function nanocomposites of porous silica-CoFe2O4-MWCNTs as a carrier for pH-sensitive anti-cancer drug controlled delivery. Dalton Trans. 2017, 46, 14831–14838. [Google Scholar] [CrossRef]
- Li, Q.; Wang, W.; Hu, G.; Cui, X.; Sun, D.; Jin, Z.; Zhao, K. Evaluation of Chitosan Derivatives Modified Mesoporous Silica Nanoparticles as Delivery Carrier. Molecules 2021, 26, 2490. [Google Scholar] [CrossRef]
- Zhang, S.; Wang, X.; Yang, J.; Chen, H.; Jiang, X. Micromechanical interlocking structure at the filler/resin interface for dental composites: A review. Int. J. Oral Sci. 2023, 15, 21. [Google Scholar] [CrossRef]
- Bergamini, S.; Bellei, E.; Generali, L.; Tomasi, A.; Bertoldi, C. A Proteomic Analysis of Discolored Tooth Surfaces after the Use of 0.12% Chlorhexidine (CHX) Mouthwash and CHX Provided with an Anti-Discoloration System (ADS). Materials 2021, 14, 4338. [Google Scholar] [CrossRef]
- Gong, S.Q.; Niu, L.N.; Kemp, L.K.; Yiu, C.K.; Ryou, H.; Qi, Y.P.; Blizzard, J.D.; Nikonov, S.; Brackett, M.G.; Messer, R.L.; et al. Quaternary ammonium silane-functionalized, methacrylate resin composition with antimicrobial activities and self-repair potential. Acta Biomater. 2012, 8, 3270–3282. [Google Scholar] [CrossRef] [PubMed]
- Luo, X.J.; Yang, H.Y.; Niu, L.N.; Mao, J.; Huang, C.; Pashley, D.H.; Tay, F.R. Translation of a solution-based biomineralization concept into a carrier-based delivery system via the use of expanded-pore mesoporous silica. Acta Biomater. 2016, 31, 378–387. [Google Scholar] [CrossRef]
- Ezzati, N.; Mahjoub, A.R.; Abolhosseini Shahrnoy, A.; Syrgiannis, Z. Amino Acid-functionalized hollow mesoporous silica nanospheres as efficient biocompatible drug carriers for anticancer applications. Int. J. Pharm. 2019, 572, 118709. [Google Scholar] [CrossRef]
- Nairi, V.; Medda, L.; Monduzzi, M.; Salis, A. Adsorption and release of ampicillin antibiotic from ordered mesoporous silica. J. Colloid Interface Sci. 2017, 497, 217–225. [Google Scholar] [CrossRef]
- Wang, D.; Xu, J.; Yang, J.; Zhou, S. Preparation and synergistic antifouling effect of self-renewable coatings containing quaternary ammonium-functionalized SiO2 nanoparticles. J. Colloid Interface Sci. 2020, 563, 261–271. [Google Scholar] [CrossRef]
- Bahrami, Z.; Badiei, A.; Atyabi, F.; Darabi, H.R.; Mehravi, B. Piperazine and its carboxylic acid derivatives-functionalized mesoporous silica as nanocarriers for gemcitabine: Adsorption and release study. Mater. Sci. Eng. C 2015, 49, 66–74. [Google Scholar] [CrossRef] [PubMed]
- Michailidis, M.; Sorzabal-Bellido, I.; Adamidou, E.A.; Diaz-Fernandez, Y.A.; Aveyard, J.; Wengier, R.; Grigoriev, D.; Raval, R.; Benayahu, Y.; D’Sa, R.A.; et al. Modified Mesoporous Silica Nanoparticles with a Dual Synergetic Antibacterial Effect. ACS Appl. Mater. Interfaces 2017, 9, 38364–38372. [Google Scholar] [CrossRef]
- Sun, R.; Zhang, J.; Whiley, R.A.; Sukhorukov, G.B.; Cattell, M.J. Synthesis, Drug Release, and Antibacterial Properties of Novel Dendritic CHX-SrCl2 and CHX-ZnCl2 Particles. Pharmaceutics 2021, 13, 1799. [Google Scholar] [CrossRef] [PubMed]
- Liu, J.; Zhang, L.; Ma, H.; Sun, H.; Ge, S.-a.; Liu, J.; Fan, S.; Quan, C. Quaternary ammonium chitosan-functionalized mesoporous silica nanoparticles: A promising targeted drug delivery system for the treatment of intracellular MRSA infection. Carbohydr. Polym. 2025, 352, 123184. [Google Scholar] [CrossRef]
- Lucchese, A.; Bondemark, L.; Marcolina, M.; Manuelli, M. Changes in oral microbiota due to orthodontic appliances: A systematic review. J. Oral Microbiol. 2018, 10, 1476645. [Google Scholar] [CrossRef] [PubMed]
- Choi, J.H.; Jung, E.H.; Lee, E.S.; Jung, H.I.; Kim, B.I. Anti-biofilm activity of chlorhexidine-releasing elastomerics against dental microcosm biofilms. J. Dent. 2022, 122, 104153. [Google Scholar] [CrossRef]
- Wang, S.; Fang, L.; Zhou, H.; Wang, M.; Zheng, H.; Wang, Y.; Weir, M.D.; Masri, R.; Oates, T.W.; Cheng, L.; et al. Silica nanoparticles containing nano-silver and chlorhexidine respond to pH to suppress biofilm acids and modulate biofilms toward a non-cariogenic composition. Dent. Mater. 2024, 40, 179–189. [Google Scholar] [CrossRef]
- Murata, H.; Koepsel, R.R.; Matyjaszewski, K.; Russell, A.J. Permanent, non-leaching antibacterial surface—2: How high density cationic surfaces kill bacterial cells. Biomaterials 2007, 28, 4870–4879. [Google Scholar] [CrossRef]
- Makvandi, P.; Jamaledin, R.; Jabbari, M.; Nikfarjam, N.; Borzacchiello, A. Antibacterial quaternary ammonium compounds in dental materials: A systematic review. Dent. Mater. 2018, 34, 851–867. [Google Scholar] [CrossRef] [PubMed]
- Imazato, S.; Kohno, T.; Tsuboi, R.; Thongthai, P.; Xu, H.H.; Kitagawa, H. Cutting-edge filler technologies to release bio-active components for restorative and preventive dentistry. Dent. Mater. J. 2020, 39, 69–79. [Google Scholar] [CrossRef]
- Karabela, M.M.; Sideridou, I.D. Synthesis and study of properties of dental resin composites with different nanosilica particles size. Dent. Mater. 2011, 27, 825–835. [Google Scholar] [CrossRef]
- Elena, P.; Miri, K. Formation of contact active antimicrobial surfaces by covalent grafting of quaternary ammonium compounds. Colloids Surf. B Biointerfaces 2018, 169, 195–205. [Google Scholar] [CrossRef]
- Gou, Y.P.; Li, J.Y.; Meghil, M.M.; Cutler, C.W.; Xu, H.H.K.; Tay, F.R.; Niu, L.N. Quaternary ammonium silane-based antibacterial and anti-proteolytic cavity cleanser. Dent. Mater. 2018, 34, 1814–1827. [Google Scholar] [CrossRef] [PubMed]
- Wilson, K.S.; Zhang, K.; Antonucci, J.M. Systematic variation of interfacial phase reactivity in dental nanocomposites. Biomaterials 2005, 26, 5095–5103. [Google Scholar] [CrossRef] [PubMed]
- Knežević, N.; Durand, J.O. Large pore mesoporous silica nanomaterials for application in delivery of biomolecules. Nanoscale 2015, 7, 2199–2209. [Google Scholar] [CrossRef]
- Mehmood, Y.; Khan, I.U.; Shahzad, Y.; Khan, R.U.; Khalid, S.H.; Yousaf, A.M.; Hussain, T.; Asghar, S.; Khalid, I.; Asif, M.; et al. Amino-decorated mesoporous silica nanoparticles for controlled sofosbuvir delivery. Eur. J. Pharm. Sci. 2020, 143, 105184. [Google Scholar] [CrossRef]
- Tejero, R.; Gutiérrez, B.; López, D.; López-Fabal, F.; Gómez-Garcés, J.; Muñoz-Bonilla, A. Tailoring Macromolecular Structure of Cationic Polymers towards Efficient Contact Active Antimicrobial Surfaces. Polymers 2018, 10, 241. [Google Scholar] [CrossRef]
- Yan, H.; Wang, S.; Han, L.; Peng, W.; Yi, L.; Guo, R.; Liu, S.; Yang, H.; Huang, C. Chlorhexidine-encapsulated mesoporous silica-modified dentin adhesive. J. Dent. 2018, 78, 83–90. [Google Scholar] [CrossRef]
- Paris, J.B.; Seyer, D.; Jouenne, T.; Thébault, P. Elaboration of antibacterial plastic surfaces by a combination of antiadhesive and biocidal coatings of natural products. Colloids Surf. B Biointerfaces 2017, 156, 186–193. [Google Scholar] [CrossRef]
- Wu, T.; Li, B.; Zhou, X.; Hu, Y.; Zhang, H.; Huang, Y.; Xu, H.H.K.; Guo, Q.; Li, M.; Feng, M.; et al. Evaluation of Novel Anticaries Adhesive in a Secondary Caries Animal Model. Caries Res. 2018, 52, 14–21. [Google Scholar] [CrossRef]
- Zandinejad, A.A.; Atai, M.; Pahlevan, A. The effect of ceramic and porous fillers on the mechanical properties of experimental dental composites. Dent. Mater. 2006, 22, 382–387. [Google Scholar] [CrossRef] [PubMed]
- Liu, Y.; Tan, Y.; Lei, T.; Xiang, Q.; Han, Y.; Huang, B. Effect of porous glass-ceramic fillers on mechanical properties of light-cured dental resin composites. Dent. Mater. 2009, 25, 709–715. [Google Scholar] [CrossRef]
- Shen, J.; Xie, H.; Wang, Q.; Wu, X.; Yang, J.; Chen, C. Evaluation of the interaction of chlorhexidine and MDP and its effects on the durability of dentin bonding. Dent. Mater. 2020, 36, 1624–1634. [Google Scholar] [CrossRef] [PubMed]
- Kiuru, O.; Sinervo, J.; Vähänikkilä, H.; Anttonen, V.; Tjäderhane, L. MMP Inhibitors and Dentin Bonding: Systematic Review and Meta-Analysis. Int. J. Dent. 2021, 2021, 9949699. [Google Scholar] [CrossRef]
- Pant, J.; Gao, J.; Goudie, M.J.; Hopkins, S.P.; Locklin, J.; Handa, H. A multi-defense strategy: Enhancing bactericidal activity of a medical grade polymer with a nitric oxide donor and surface-immobilized quaternary ammonium compound. Acta Biomater. 2017, 58, 421–431. [Google Scholar] [CrossRef]
- Yao, Y.; Ye, Z.; Zhang, Y.; Wang, Y.; Yu, C. Quaternary Ammonium Compounds and Their Composites in Antimicrobial Applications. Adv. Mater. Interfaces 2024, 11, 2300946. [Google Scholar] [CrossRef]
- Barman, S.; Konai, M.M.; Samaddar, S.; Haldar, J. Amino Acid Conjugated Polymers: Antibacterial Agents Effective against Drug-Resistant Acinetobacter baumannii with No Detectable Resistance. ACS Appl. Mater. Interfaces 2019, 11, 33559–33572. [Google Scholar] [CrossRef]
- Nadagouda, M.N.; Vijayasarathy, P.; Sin, A.; Nam, H.; Khan, S.; Parambath, J.B.M.; Mohamed, A.A.; Han, C. Antimicrobial activity of quaternary ammonium salts: Structure-activity relationship. Med. Chem. Res. 2022, 31, 1663–1678. [Google Scholar] [CrossRef]
- Van de Vliet, L.; Vackier, T.; Thevissen, K.; Decoster, D.; Steenackers, H.P. Imidazoles and Quaternary Ammonium Compounds as Effective Therapies against (Multidrug-Resistant) Bacterial Wound Infections. Antibiotics 2024, 13, 949. [Google Scholar] [CrossRef] [PubMed]
- Song, J.; Kong, H.; Jang, J. Bacterial adhesion inhibition of the quaternary ammonium functionalized silica nanoparticles. Colloids Surf. B Biointerfaces 2011, 82, 651–656. [Google Scholar] [CrossRef] [PubMed]
- Rodríguez, H.A.; Giraldo, L.F.; Casanova, H. Formation of functionalized nanoclusters by solvent evaporation and their effect on the physicochemical properties of dental composite resins. Dent. Mater. 2015, 31, 789–798. [Google Scholar] [CrossRef] [PubMed]
- Zhang, X.; Zhang, Q.; Meng, X.; Ye, Y.; Feng, D.; Xue, J.; Wang, H.; Huang, H.; Wang, M.; Wang, J. Rheological and Mechanical Properties of Resin-Based Materials Applied in Dental Restorations. Polymers 2021, 13, 2975. [Google Scholar] [CrossRef]
- Li, Y.; Wang, X.; Lv, X.; Wang, X.; Wang, X.; Cui, J.; Yan, M. Extractions and rheological properties of polysaccharide from okra pulp under mild conditions. Int. J. Biol. Macromol. 2020, 148, 510–517. [Google Scholar] [CrossRef]
- Alfei, S.; Marengo, B.; Zuccari, G.; Turrini, F.; Domenicotti, C. Dendrimer Nanodevices and Gallic Acid as Novel Strategies to Fight Chemoresistance in Neuroblastoma Cells. Nanomaterials 2020, 10, 1243. [Google Scholar] [CrossRef]
- Bruschi, M.L. (Ed.) Mathematical models of drug release. In Strategies to Modify the Drug Release from Pharmaceutical Systems; Woodhead Publishing: Sawston, UK, 2015; pp. 63–86. [Google Scholar]
- Zuccari, G.; Alfei, S.; Zorzoli, A.; Marimpietri, D.; Turrini, F.; Baldassari, S.; Marchitto, L.; Caviglioli, G. Increased Water-Solubility and Maintained Antioxidant Power of Resveratrol by Its Encapsulation in Vitamin E TPGS Micelles: A Potential Nutr. Suppl. Chronic Liver Disease. Pharmaceutics 2021, 13, 1128. [Google Scholar] [CrossRef]

| ARI | ||||||
|---|---|---|---|---|---|---|
| 0 | 1 | 2 | 3 | M (P25, P75) | p | |
| 3M | 1 | 4 | 17 | 8 | 2 (2, 3) | a |
| Control | 6 | 8 | 7 | 9 | 1 (2, 3) | a |
| 5 wt% QLMSN@CHX | 1 | 2 | 18 | 19 | 2 (2, 3) | a |
Disclaimer/Publisher’s Note: The statements, opinions and data contained in all publications are solely those of the individual author(s) and contributor(s) and not of MDPI and/or the editor(s). MDPI and/or the editor(s) disclaim responsibility for any injury to people or property resulting from any ideas, methods, instructions or products referred to in the content. |
© 2025 by the authors. Licensee MDPI, Basel, Switzerland. This article is an open access article distributed under the terms and conditions of the Creative Commons Attribution (CC BY) license (https://creativecommons.org/licenses/by/4.0/).
Share and Cite
Teng, X.; Cao, Y.; Mao, J.; Luo, X. Dual-Mode Antibacterial Orthodontic Composite: Contact-Killing QACs and Sustained CHX Release via Large-Pore Mesoporous Silica Nanoparticles. Int. J. Mol. Sci. 2025, 26, 6172. https://doi.org/10.3390/ijms26136172
Teng X, Cao Y, Mao J, Luo X. Dual-Mode Antibacterial Orthodontic Composite: Contact-Killing QACs and Sustained CHX Release via Large-Pore Mesoporous Silica Nanoparticles. International Journal of Molecular Sciences. 2025; 26(13):6172. https://doi.org/10.3390/ijms26136172
Chicago/Turabian StyleTeng, Xiaotian, Yingguang Cao, Jing Mao, and Xiaojuan Luo. 2025. "Dual-Mode Antibacterial Orthodontic Composite: Contact-Killing QACs and Sustained CHX Release via Large-Pore Mesoporous Silica Nanoparticles" International Journal of Molecular Sciences 26, no. 13: 6172. https://doi.org/10.3390/ijms26136172
APA StyleTeng, X., Cao, Y., Mao, J., & Luo, X. (2025). Dual-Mode Antibacterial Orthodontic Composite: Contact-Killing QACs and Sustained CHX Release via Large-Pore Mesoporous Silica Nanoparticles. International Journal of Molecular Sciences, 26(13), 6172. https://doi.org/10.3390/ijms26136172

